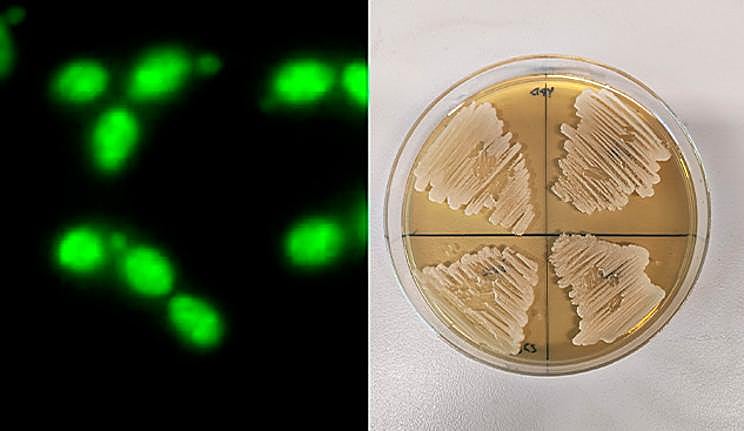
Cepa de estudio C. albicans en placa.

La USAL avanza en el estudio de Candida albicans, principal causa de infección fúngica en hospitales
El microbiólogo de la Universidad de Salamanca Víctor Arribas estudia nuevas dianas terapéuticas para el desarrollo de tratamientos antifúngicos en colaboración con la Universidad Complutense de Madrid
Candida albicans es un patógeno oportunista que forma parte de la microbiota de la piel, el intestino y las mucosas. En individuos inmunocomprometidos puede causar candidiasis invasiva, una infección potencialmente mortal que sigue siendo la principal causa de infección fúngica en hospitales. Esta micosis oportunista afecta significativamente a pacientes con cáncer, postoperatorios y en cuidados intensivos, generando costos considerables en la atención médica. Sin embargo, el tratamiento de la candidiasis invasiva está obstaculizado por la limitada disponibilidad de medicamentos antifúngicos y el desarrollo de mecanismos de resistencia a estos fármacos.
En este contexto de urgente necesidad de descubrir dianas terapéuticas para el desarrollo de nuevos antifúngicos, la Universidad de Salamanca y la Universidad Complutense de Madrid desarrollan en colaboración el estudio 'Unravelling the Role of Candida albicans Prn1 in the Oxidative Stress Response through a Proteomics Approach', que revela la importancia de la proteína Prn1 en la respuesta al estrés oxidativo de Candida albicans y cómo en ausencia de la proteína aumenta la apoptosis o muerte celular programada en el microorganismo.
Los resultados del trabajo, recogido en la publicación 'Antioxidants' de la editorial de revistas científicas de acceso abierto MDPI, indican que «Prn1 podría ser considerada a estudio como una posible diana terapéutica en el desarrollo de nuevos tratamientos antifúngicos», explica Arribas.

Cuando la proteína está ausente, las células «tienen más dificultades para combatir el daño causado y son más propensas a morir por una agente oxidante como el peróxido de hidrógeno (agua oxigenada), que es el producido por las células del sistema inmunitario como los macrófagos». En palabras del científico, «esto sugiere que esta proteína es esencial para proteger a la célula de daños oxidativos y mantener su supervivencia cuando son atacadas por el sistema inmune».
Comprendiendo el proteoma de C. Albicans
El proyecto de investigación, de dos años de duración, fue ejecutado en colaboración del grupo de investigación del Departamento de Microbiología y Parasitología dirigido por la Dra. Concha Gil, catedrática de la Universidad Complutense de Madrid (UCM), y con la Unidad de Proteómica del CAI de Técnicas Biológicas de la misma universidad.
Concretamente, el trabajo se centró en el estudio de la respuesta de C. albicans frente a los macrófagos «mediante técnicas de proteómica diferencial que ayudaran a comprender con mayor precisión los cambios en el proteoma de C. Albicans después de la interacción con los mismos», subraya Arribas.
Para ello, dispusieron de técnicas microbiológicas para estudiar el fenotipo de las células de C. albicans que no tienen la proteína Prn1 cuando se las expone al estrés oxidativo que produce el agua oxigenada (que imita la acción oxidante de las células del sistema inmunitario como los macrófagos).
Además, en colaboración con la Unidad de Citometría de Flujo y Microscopia de Fluorescencia de la UCM, se emplearon técnicas de cultivo y la citometría de flujo para determinar la muerte celular de las células de C. albicans en respuesta al agente oxidante y se utilizó, también, la microscopía de fluorescencia para determinar presencia de agentes oxidantes en el interior celular.
Para el estudio de la expresión diferencial de las proteínas de estas células mutantes sin la proteína Prn1, la principal metodología utilizada fue la espectrometría de masas que «nos ayudó a determinar la abundancia relativa de las proteínas dentro de la célula en presencia y ausencia del agua oxigenada», indica.






